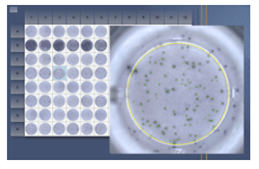

AID Classic Elispot reader
【使用最廣泛的可見光盤分析設備】
快速、效率、用戶友善的分析設備,是 AID 經典的一款基礎 Elispot Reader,為市場上最成功的設備之一。
使用最廣泛的基礎分析設備
- AID Classic 支援 96-well 與 384-well 盤型分析,包含不同品牌的membrane type plates、ELISA-style plates 與 low volume plates。
- 可同時擷取高解析度影像、自動對準孔位中心、計數與分析,以及匯出多種數據格式。
規格與特性
| 相機 | 規格 | 科研儀器專用光學鏡頭 |
| 像素 | 五百萬 | |
| 光源光源 | 可見光 | 均勻散光長效環形 LED |
| 應用 |
| |
| 特點 |
| |
相關連結